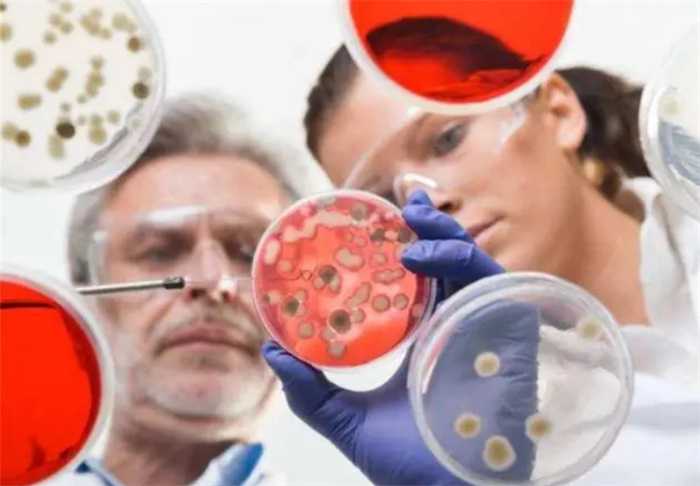

为延长生命 科学家给自己注射350万年前的细菌 结果如何
表现出更具年轻化特征,但是实际效果没有那么明显。在古往今来,许多有权势或财富的人一直追求着永生。古代帝王为了延长寿命,往往会听信术士的话,尝试通过服用炼制的丹药来达到延寿的目的。然而,这些渴求长生的帝王最终却活得很短。吃药来延长寿命并不明智。

现代科学发展的认识是,基因是决定人类寿命的关键因素。尽管基因编辑技术不断成熟,但我们仍然无法突破人类寿命的上限。目前,人类的平均寿命已经显著增长,借助先进的医疗技术和科学养生方法,个体寿命可以超过百岁。吉尼斯世界纪录中最长寿命记录为122岁。
科学家发现,人类的寿命可能还可以更长,但始终无法突破寿命的上限。这一上限似乎是人类固有的属性,除非依靠外部干预手段,否则人的寿命无法超越这个上限。

然而,总有些人不满足这样的设定,为了追求更长的寿命,一些人不惜冒险进行实验,尝试延长寿命的药物。在俄罗斯,有一位科学家用自己做实验,将350万年前的细菌注射到自己体内,因为这种细菌能使实验对象充满活力。
这位科学家名叫阿纳托纳-布朗科夫,于2009年在西伯利亚冻土层中发现了一只冰冻了350万年的猛犸象头部,发现了一种活跃的细菌芽孢杆菌F。对这种细菌很感兴趣的他,进行了一系列实验,发现感染作物后,作物更加充满生机;感染白鼠和果蝇后,实验对象表现出更年轻的特征。
鉴于实验结果的预期效果,他猜测这种细菌对人体也会产生类似的效果,于是将基因排序后的芽孢杆菌F注射进自己体内。这样罕见的自我实验例子,在历史上极为罕见,尤其是涉及延长寿命的实验,更显得引人注目。
人们关注布朗科夫之后的变化,根据他的说法,注射芽孢杆菌F后,他的身体出现了恢复年轻状态的效果,两年间没有生过病,精力也更加充沛。一些效仿他的人注射这种细菌后,也表现出更具年轻化特征。
然而,实际效果可能没有那么显著。虽然注射过这种细菌的人感觉更年轻了,但外表并未有明显的变化,白发和皱纹等老年化特征并未发生明显改变。注射这种细菌或许能增强机体免疫力,但要逆转衰老,可能需要从基因层面着手。
要想突破寿命上限,人类可能需要在宇宙中寻找答案。人类已经对衰老原因有了明确认识,个体细胞中的自由基增多,会导致细胞衰老和凋亡。染色体端粒的缩短也会导致细胞无法正常分裂,无法补充新细胞。
下一篇:乌克兰更改圣诞节日期
大家都在看
-
民间奇闻:长平镇的“怪”猫 《二》 自从堂屋出现诡异猫爪印后,老陈家的怪事非但没有消停,反而一天比一天凶险,整座老宅子都透着一股说不出的阴冷。陈老太夜夜点灯熬到天亮,不敢合眼,心里清楚,自家那只四蹄踏雪的黑猫,绝对不是正常死亡。那只黑猫 ... 奇闻怪事06-12
-
古槐血案:百年冤屈终得雪(真实民间奇闻) 清末光绪年间,天津城郊有户农家,新媳妇过门半月,公婆相继离奇暴毙——无病腹痛、浑身抽搐,郎中查不出半分病因。 全村流言炸开,都指新媳妇“八字克亲”,说她下毒弑亲。新媳妇百口莫辩,被绑送县衙,受尽唾骂, ... 奇闻怪事06-11
-
历史人文·奇闻旧事:课本不写的真实往事,件件颠覆认知 大家好我是平安喜乐,每天给大家带来最新动态,内容随缘更,每篇都掏干货;如果你觉得这些信息对生活有用,就点个关注~历史从不是课本里那几行冰冷的文字、几个刻板的人物标签,也不是只有王朝更迭、金戈铁马的宏大 ... 奇闻怪事06-10
-
民间奇闻:长平镇的“怪”猫 《三》 老师傅的一番话,彻底解开了老陈家连日来的诡异谜团,也让所有人心头又酸又惊。原来长平镇老陈家夜夜频发的怪事,从来不是灵异作祟,而是一场跨越生死的守护。老师傅告诉陈老太,老宅背靠荒山,屋后老槐树下常年聚阴 ... 奇闻怪事06-09
-
奇闻异事:富二代从外面请东西回来后暴毙 今天老财讲故事------本期内容源自网络民间故事,由某位网友匿名分享。有人花大价钱从外面请了东西回来,生意确实翻红了,钱也赚到了手,可没过几个月人就没法了。出殡那天当众把那东西烧掉的时候,在场几个人听得真 ... 奇闻怪事06-08
-
奇闻异事:25岁年轻女孩,在酒吧被人扯头发,暗下“春梦蛊” 今天老财讲故事------那天晚上,月瑶被闺蜜拽去新开的酒吧,音乐震得心脏发麻。一个穿着花衬衫的男人凑过来,胳膊“不小心”搭上她肩膀的瞬间,月瑶猛地推开他,头皮却像被细铁丝钩了一下,刺刺地疼。她当时只骂了句 ... 奇闻怪事06-08
-
奇闻!老汉街头卖自己,十两银子卖出万贯家业和亲生儿子! 明朝正德年间,浙东婺州府有个远近闻名的大财主,姓周名善。周家世代勤恳朴实,祖祖辈辈深耕田地、勤俭持家,日积月累攒下了万贯家财、良田千亩,是当地数一数二的富庶人家。可富贵之家,也有难言的遗憾。周善娶妻数 ... 奇闻怪事06-06
-
广东乡村奇闻!老实人常年帮孤寡,一场大雨救了全家富贵 文/空心菜古时候,广东湛江一带的乡村,民风淳朴,村里人大多老实本分,日出而作、日落而息。村里有个年轻后生,名叫陈老实。人如其名,他性子憨厚,嘴巴笨,不会占便宜,也不会耍心眼,一辈子老老实实种地过日子。 ... 奇闻怪事06-06
-
2026世界杯未开先火,七大奇闻刷新足坛认知 2026世界杯未开先火,七大奇闻刷新足坛认知 2026年美加墨世界杯尚未鸣哨,赛场内外已涌现诸多破天荒的奇观,每一件都足以让球迷大跌眼镜,成为足坛热议的焦点。 本届世界杯开创历史先河,首次由美国、加拿大、墨西哥 ... 奇闻怪事06-06
-
粤地乡间奇闻:过阴匠人替人寻亲,临终秘语藏人心因果 文/空心菜在广东粤乡老一辈人的口中,一直流传着一门古老行当,本地人称之为过阴匠人。并非坊间谣传的阴阳怪谈、虚妄灵异,实则是旧时乡间一类心思极细、记性极好、善于安抚人心的长者。他们常年听遍乡中旧事、见证 ... 奇闻怪事06-06
相关文章
- 奇闻异事:富二代从外面请东西回来后暴毙
- 奇闻异事:25岁年轻女孩,在酒吧被人扯头发,暗下“春梦蛊”
- 奇闻!老汉街头卖自己,十两银子卖出万贯家业和亲生儿子!
- 广东乡村奇闻!老实人常年帮孤寡,一场大雨救了全家富贵
- 2026世界杯未开先火,七大奇闻刷新足坛认知
- 粤地乡间奇闻:过阴匠人替人寻亲,临终秘语藏人心因果
- 广东民间奇闻!妻子举止怪异夜夜外出,婆婆看破不说破藏大祸
- 平陆县奇闻轶事
- 世界奇闻[第2集]-岭南美术出版社1986 《周末》画报编辑部编
- 世界奇闻[第1集]-岭南美术出版社1986 《周末》画报编辑部编
- 《千古奇闻!历史上最离谱的3件荒唐事》
- 东北流传的奇闻与秘事
- 古人流传的奇闻异事
- 陈应松短篇小说:山中奇闻
- 大千世界无奇不有:全网刷屏的五月奇闻趣事,每一件都颠覆认知
- 民间真实奇闻:怪事接连发生,老一辈闭口不敢提
- 近期现实版奇闻趣事大赏,个个新鲜离谱,看完笑到停不下来!
- 历史上的那些奇闻轶事——分享历史趣闻和轶事,增强趣味性
- 趣话历史:那些鲜为人知的奇闻轶事
- 中国古代野史五例奇闻异事
热门阅读
-
日本gv公司盘点,高质量钙片清秀型美攻美受 07-11
-
盘点中国十大龙现身事件,真龙竟然屡次现身震惊众人 06-27
-
戴旭说出马航失联真相,因为害怕承担责任迟迟不公开 07-05
